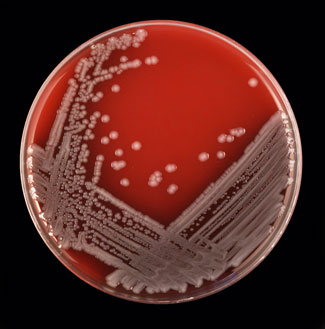
E. coli creixent en agar

Les noies de classes populars i els poders en el camp de l'educació
Els resultats d'aquesta tesi evidencien la fragilitat de l'èxit escolar de les dones en tots els nivells educatius. Ressalten també les contradiccions de l'avenç en la igualtat de les noies a l'escola i de l'experiència...